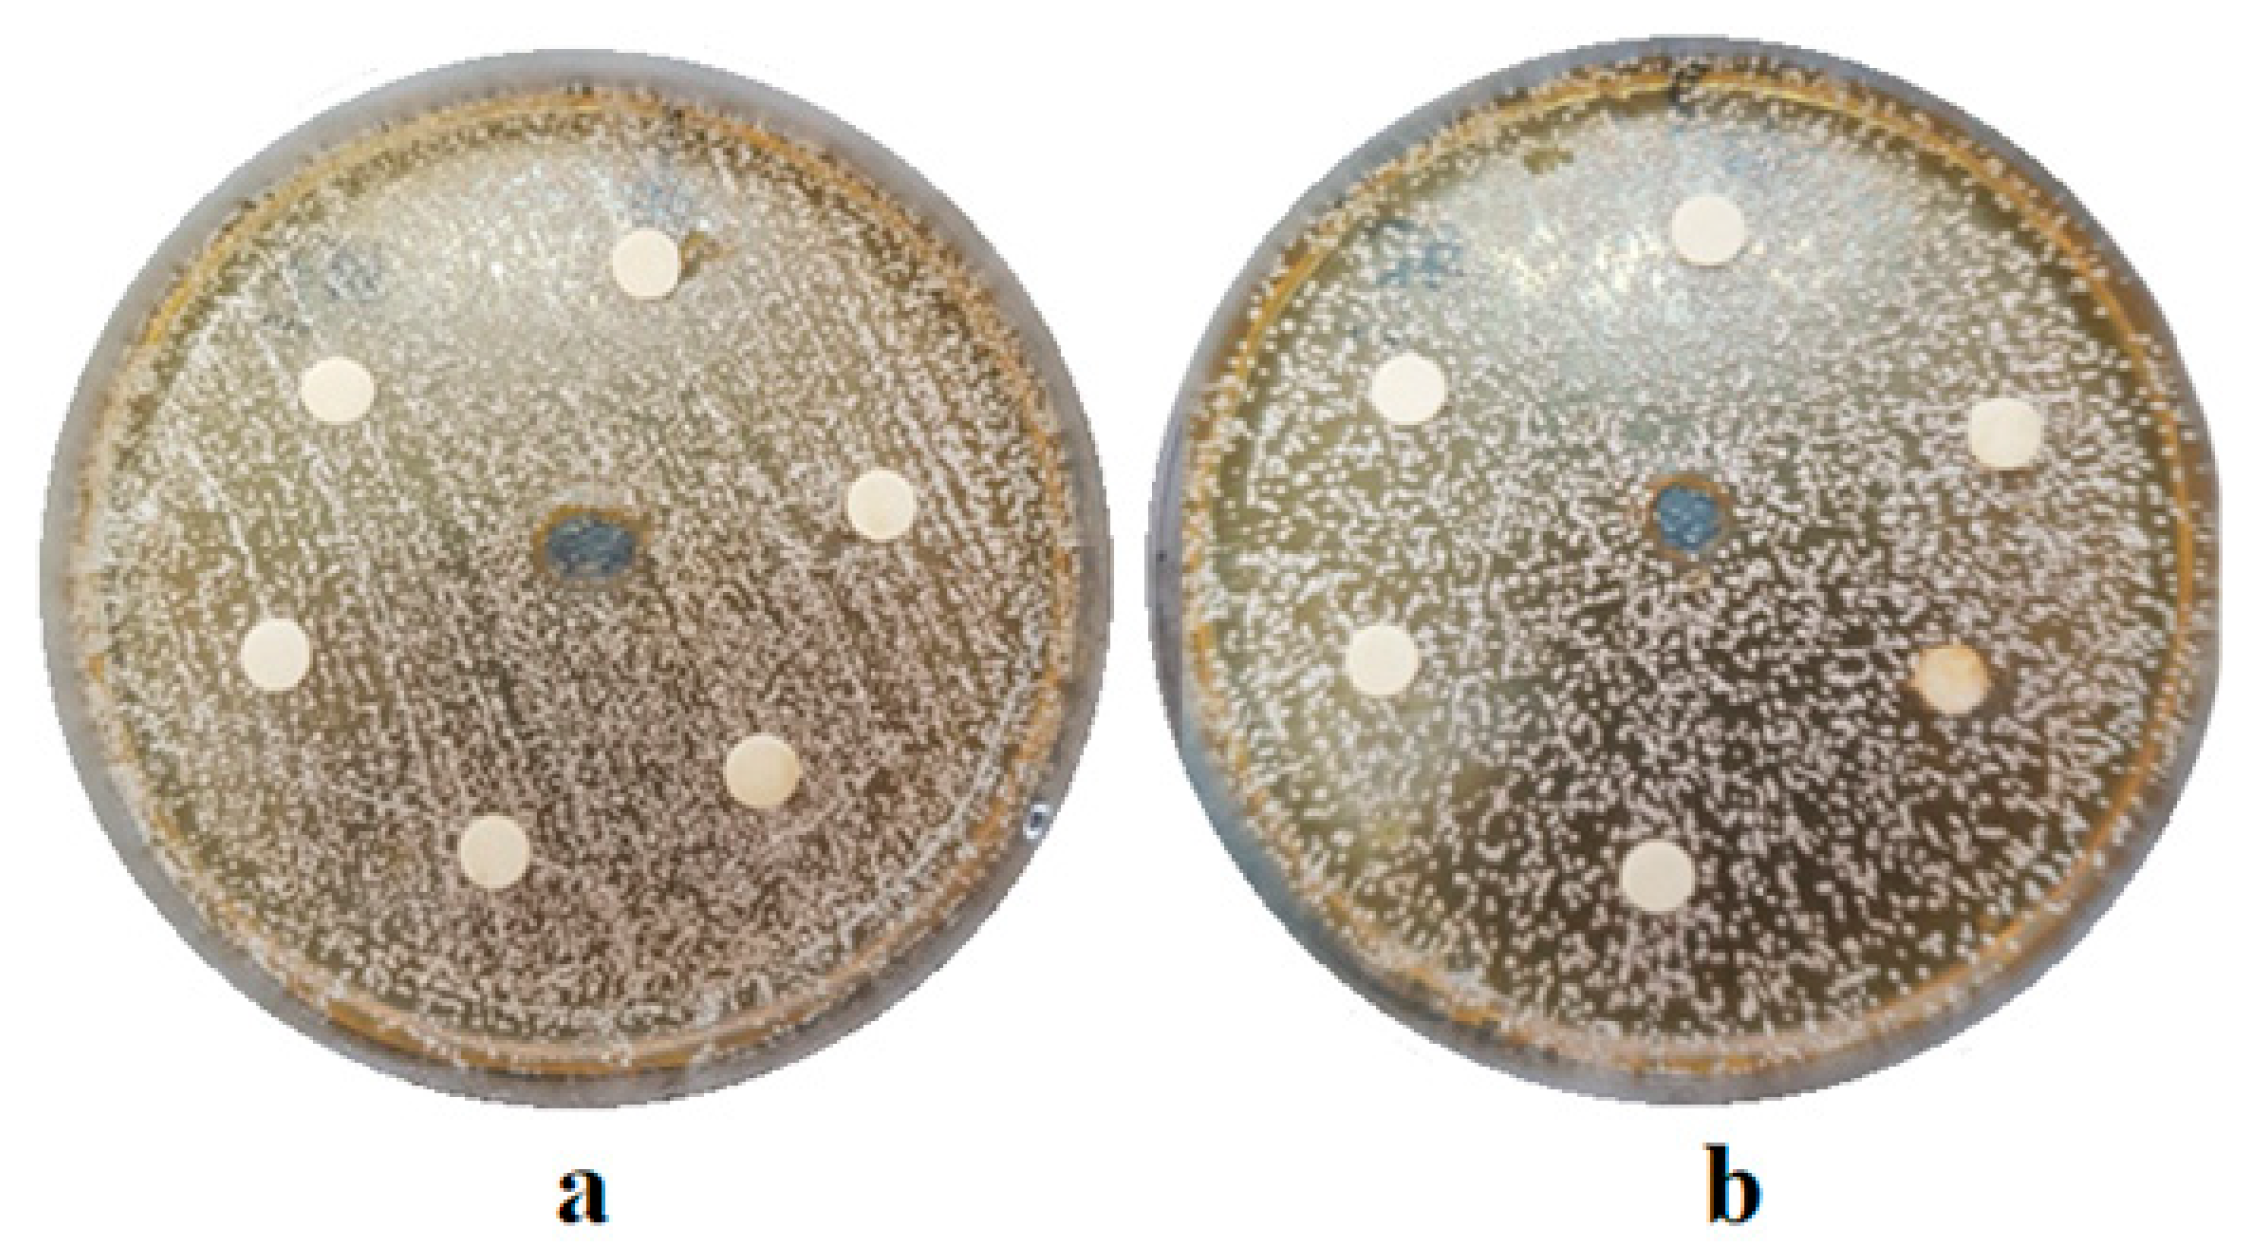
Coatings 10 00537 g006

1. Introduction
Green tea is the most consumed beverage, after water [
1], and it is obtained by infusing in hot water the dried leaves of
Camellia sinensis, a plant belonging to the Theaceae family. This plant is evergreen, and it is cultivated in tropical and subtropical climates, especially in China, Sri Lanka and Japan [
2].
Previous studies in the literature have associated green tea with multiple therapeutic effects. It has a strong antioxidant action due to its catechin content and also contains condensed and hydrolysable tannins, which are also responsible for some therapeutic effects [
3].
It was demonstrated that EGCG (epi—gallo—catechin—gallate) has the role of inhibiting the growth of microorganisms responsible for inflammation and bone resorption, according to in vitro studies on green tea catechins, regarding periodontal disease [
4]. It has also been suggested that green tea catechins (EGCG) offer a promising prospect for the development of a new adjuvant treatment for chronic marginal periodontitis due to their ability to decrease the secretion of MMP (matrix-metalloproteinase), which are important tissue-destroying enzymes produced by mucous membranes and immune cells [
5].
In endodontics, an herbal irrigation solution is needed because of the side effects, especially the toxicity, of the most used irrigants. Green tea has shown in some in vitro studies an antibacterial effect on the biofilm
Enterococcus faecalis, which is the most common species isolated from the root canal of teeth with refractory and recurrent apical periodontitis [
6,
7,
8].
Nowadays, the concerns of dentists and patients have increasingly focused on improving the aesthetic appearance of teeth. Procedures commonly used in dental clinics include tooth whitening. This is a relatively safe clinical procedure, well received by patients, but not without undesirable side effects.
The products used for bleaching have carbamide peroxide as their main active ingredient. In contact with oral fluids, it decomposes into water, urea and oxygen, which by oxidation exerts the whitening effect. Dental sensitivity is one of the most common side effects due to the action of oxygen free radicals [
9] resulting from the decomposition of carbamide peroxide [
10]. Some studies explain this by the ability of peroxide to diffuse through dentinal tubes to the pulp chamber [
11].
Additionally, Gonzales et al. demonstrated, in their histological research, the existence of slight inflammatory modification into the pulp tissue [
12].
Another adverse effect of the tooth bleaching procedure is the morphological alterations of the enamel [
13]. Other studies have shown changes in tooth enamel after whitening due to the loss of calcium ions from its structure [
14].
The research in this study aimed to prepare and characterize a new product for the protection of dental hard tissues after the tooth bleaching procedure. This preparation is represented by the natural extract from green tea leaves (Camellia sinensis). The antibacterial studies proposed in this study and performed in vitro test the antimicrobial efficacy of the experimental extract against the main microorganisms responsible for the production of dental caries and other endodontic or periodontal diseases. Additionally, we followed in this study the effect of the experimental gel on the surface roughness of tooth enamel following the teeth whitening process, which is known from the literature as a procedure extremely requested by patients, but with undesirable side effects, in mainly surface lesions of the enamel, which over time can promote or even trigger carious lesions.
The objectives of this study were to test the antimicrobial and antifungal action of an experimental extract based on Camellia sinensis on bacterial and fungal strains commonly identified on hard dental tissues, as well as to evaluate the effect of the experimental extract on surface roughness of bleached enamel with carbamide peroxide based gels.
2. Materials and Methods
2.1. Materials
Twenty-eight healthy third molars, extracted for orthodontic purposes, were taken in the present study and randomly divided into four experimental groups as follows: one group of healthy, untreated teeth, which served as a control group, a group of stained but not bleached teeth, which served as a stained control group and two groups of teeth designated as experimental groups. For this study we received approval from the Ethics Commission of the University of Medicine and Pharmacy Cluj-Napoca, under approval number 180/06.05.2020.
We also used for this study Opalescence 16%, a carbamide peroxide (PC) whitening gel provided from Ultradent Products (South Jordan, UT, USA), and we prepared and used experimental green tea extract and experimental bleaching gel.
The present study was performed on 4 microbiological strains from ATCC (American Type Culture Collection) accredited cultures, purchased from Microbiologics, St. Cloud, Minnesota, USA. These are Streptococcus mutans (ATCC 251175), Peptostreptococcus anaerobius (ATCC 27337), Corynebacterium xerosis (ATCC 373) and Candida albicans (ATCC 10231).
2.2. Preparing the Experimental Extract of Camellia Sinensis and the Experimental Bleaching Gel
The green tea extract was developed within the “Raluca Ripan” Chemistry Research Institute of the Babes-Bolyai University of Cluj-Napoca. Four experimental extracts of different concentrations were made with different infusion times of the plant as follows: in three batches of 100 mL of boiled distilled water were added 35 g, 40 g and 50 g green tea leaves (R. Twining and Company Limited, London, UK).
The 35% extract solution was left to infuse for 15 min, the 40% solution for 30 min, and the 50% extract was infused for 60 min. The fourth extract was prepared as follows: 20 g of green tea leaves were added to 200 mL of boiled distilled water and infused for 10 min. Subsequently, the products were filtered to remove possible impurities and stored in sterile containers at 4 °C for later use. To obtain the experimental bleaching gel, 16% carbamide peroxide was added to the extract solution.
2.3. Growth of the Studied Bacterial and Fungal Strains
To obtain the study cultures, strains from ATCC (American Type Culture Collection) accredited cultures were cultured on specific culture media. Thus, Corynebacterium xerosis (ATCC 373) was inoculated on the culture medium tryptic soy agar with 5% sheep blood (Biomerieux, Lyon, France) for 48 h at a temperature of 35 ± 1 °C in an atmosphere of 5% CO2, after which the colonies were replicated on the same media and in the same conditions (48 h, 35 ± 1 °C, 5% CO2) to obtain the working culture. Special CO2-generating bags (GenBag CO₂, Biomerieux, Lyon, France) were used to obtain the specific growth atmosphere.
Streptococcus mutans (ATCC 25175) was inoculated on agar with 5% sheep blood media culture (Biomerieux, Lyon, France) and incubated for 48 h at 35 ± 1 °C in the atmosphere 5% CO₂ (GenBag CO2, Biomerieux, Lyon, France). The culture was replicated on the same culture media and in the same conditions, obtaining the working culture after another 48 h.
Peptostreptococcus anaerobius (ATCC 27337) was inoculated on anaerobic blood agar (Scaedler and Brucella Blood Agar), Biomerieux, Lyon, France, then incubated at 35 °C in an anaerobic atmosphere for 48 h (GenBag anaerobic, Biomerieux, Lyon, France). It was then replicated on the same medium and in the same conditions, and the working culture was obtained after another 48 h.
Candida albicans (ATCC 10231) was cultivated on Sabourand agar medium (Biomerieux, Lyon, France) for 48 h at 37 °C. The culture was replicated and cultivated under the same conditions, obtaining the working culture.
2.4. Preparation of Dental Specimens
The 28 molars under study were mounted in self-curing acrylate prisms (Duracryl Plus, Spofadental Inc, Jičín, Czech Republic) up to the enamel–dentin junction level, keeping the entire coronary portion free.
2.5. Staining Protocol
The two experimental groups and the control stained group were subjected to a staining process, the molars being immersed in coffee solution 8 h/day, for 3 consecutive days. The coffee solution was prepared in the Saeco Pico Baristo machine in espresso mode using 5 g of Lavazza coffee (Luigi Lavazza SpA, Torino, Italy) per 100 mL of water. A freshly brewed coffee solution was used at each staining session. Between staining sessions, the teeth were kept immersed in artificial saliva at 37 °C.
2.6. Bleaching Protocol
The bleaching protocol aimed to simulate a whitening treatment at home using individualized trays. Thus, 16% carbamide peroxide whitening gel (Opalescence 16%, Ultradent Products, South Jordan, UT, USA) was applied to the Opalescence gel group for 6 h/day, for 7 consecutive days. The experimental gel study group underwent experimental bleaching gel for 6 h/day for 7 consecutive days. At the end of each bleaching session, the teeth were washed for 60 s under running water and then stored in artificial saliva at 37 °C.
At the end of the experiment, slices from the vestibular part of the molars from each study group were taken in order to analyze the appearance of the enamel by scanning electron microscopy and atomic force microscopy.
2.7. Determination of Antibacterial and Antifungal Activity
To determine the antibacterial activity of the experimental solutions, we used the standard procedure recommended by EUCAST, meaning the diffusimetric method (Eucast Disk Diffusion Method for Antimicrobial Susceptibility Testing, version 8.0, January 2018).
Working cultures of Corynebacterium xerosis (ATCC 373) and Streptococcus mutans (ATCC 25175) were inoculated on Mueller–Hinton Agar medium with 5% defibrinated horse blood (Biomerieux, Lyon, France) and 20 mg/L β–NAD (Mueller–Hinton F, Biomerieux, Lyon, France). The two bacterial cultures were incubated at a temperature of 35 ± 1 °C for 18 ± 2 h in an atmosphere of 5% CO₂ (GenBag CO₂, Biomerieux, Lyon, France).
The culture of Peptostreptococcus anaerobius (ATCC 27337) was inoculated on brucella blood agar culture media (Biomerieux, Lyon, France) and incubated at 35 °C in an anaerobic atmosphere (anaerobic GenBag, Biomeriex, Lyon, France) for 48 h.
The culture of Candida albicans (ATCC 10231) was grown on Sabouraud medium (Biomerieux, Lyon, France) and 0.5 mL McFarland inoculum and incubated at 30 °C for 72 h.
After obtaining the test cultures, we impregnated sterile antibiogram discs (Oxoid, Hamptshire, UK) with different concentrations of green tea extract or we created sterile wells with a diameter of 6 mm on the culture media plate, reading the diameters of the inhibition zones. Clear areas of inhibition around each disc/well revealed the presence of antimicrobial activity for each solution used. For each concentration and amount inoculated, 7 repeated determinations were performed. In order to determine the antimicrobial effect of the experimental extract, according to the CLSI (Clinical and Laboratory Standards Institute) standards, it was necessary to determine the standard reference values of the inhibition zones for each bacterial and fungal strain.
For this, we used impregnated discs with standard antimicrobial substances, according to CLSI, from Bio-Rad, Hercules, CA, USA, as follows: for Corynebacterium xerosis (ATCC 373) and Streptococcus mutans (ATCC 25175) we used benzylpenicillin 1 unit, clindamycin 2 µg, vancomycin 5 µg, gentamicin 10 µg and ampicillin 2 µg. Streptococcus pneumoniae (ATCC 49619) strain purchased from Microbiologics, St. Cloud, Mn, USA, was used for internal quality control. The control strain was inoculated onto Mueller–Hintor Agar culture media with 5% defibrinated horse blood (Biomerieux, Lyon, France) and 20 µg/L β-NAD (Mueller–Hinton F, Biomerieux, Lyon, France). After obtaining the working cultures, the discs impregnated with antibiotic specific for each microbial strain were placed in plates, reading the diameters of the inhibition zones after 48 h. Although not standardized for anaerobes, we also used the diffusimetric method to test Peptostreptococcus anaerobius (ATCC 27337) grown on brucella blood agar (Biomerieux, Lyon, France) and incubated in an anaerobic atmosphere (GenBag anaerobic, Biomerieux, Lyon, France).
2.8. SEM and AFM Analysis of Tooth Specimens
All study groups were evaluated by scanning electron microscopy (SEM) to highlight the change in tooth surface as a result of staining and then whitening treatment. For comparison, we used as a control the group of teeth not subjected to the processes of staining and bleaching. The samples were examined using an Inspect-S microscope (FEI Company, Hillsboro, OR, USA). Several image enlargement units were used, and the recordings were made on the surface of the tooth enamel. Atomic force microscopy (AFM) was performed using a JEOL JSPM 4210 scanning probe microscope, Japan. The topographic images were recorded in tapping mode using NSC 15 cantilevers produced by Micromasch Co. Bulgaria (resonant frequency 325 kHz and force constant 40 N/m). The enamel microstructure was scanned at an area of 5 µm × 5 µm at a scan rate of about 1 Hz, and the nanostructure was scanned at area of 1 µm × 1 µm at a rate of 1.5–2 Hz. The AFM topographic images were processed using WinSPM 2.0 Processing soft powered by JEOL for the AFM microscopes. For each slice of tooth examined, 7 repeated determinations were performed.
2.9. Statistical and Mathematical Methods
The SPSS software package version 21.0 (SPSS Inc., Chicago, IL, USA) was used for statistical analysis and graphical representations. The acceptable error threshold was α = 0.05. To describe continuous quantitative data, we used arithmetic mean, standard deviation (SD), minimum, maximum and standard error. The Kruskal–Wallis ANOVA test was used to test the differences between the independent groups investigated. The Mann–Whitney test was used in the post-hoc analysis when significant differences were identified by the Kruskal–Wallis ANOVA test. The Spearmann correlation coefficient was calculated to determine the links between quantitative variables and a non-normal distribution within the groups. Colton’s rules were used to interpret the correlation coefficient.
3. Results
The experimental extract of
Camellia sinensis developed in the present study was evaluated from a microbiological point of view by testing the antimicrobial activity on different microbial strains frequently identified in the oral cavity. The diffusimetric method is based on the property of antimicrobial substances to diffuse in a solid culture media, on which the bacterial culture to be tested is cultivated. The interpretation was made according to the diameter of the inhibition zone, measured with a ruler, including the diameter of the well/disc. The values obtained in millimeters assessed the strain as sensitive, intermediately sensitive or resistant to the test substance (
Figure 1,
Figure 2 and
Figure 3).
It was necessary to relate the values recorded to the standard reference values of the inhibition zones for each tested microbiological strain in order to determine the antimicrobial effect of the experimental extract, according to CLSI (Clinical and Laboratory Standards Institute) norms. These are shown in
Table 1.
The mean values of the zones of inhibition, after measuring the inhibition diameters in mm for the strain
Peptostreptococcus anaerobius (ATCC 25337) and for the strain
Corynebacterium xerosis (ATCC 373), are illustrated in
Figure 4.
The mean values of the inhibition zones, after measuring the inhibition diameters in mm for the
S. mutans (ATCC 25175) strain, are illustrated in
Figure 5.
On the
Candida albicans (ATCC 10231) strain, the experimental extracts did not exert any antifungal effect, as illustrated in
Figure 6.
Figure 7 shows the microstructural aspects specific to the untreated healthy enamel. Its aspect was characterized by a relatively smooth surface that showed signs of tooth wear due to the abrasive effect of mastication correlated with the acidity of food (
Figure 7a). These were manifested by the erosion and dislocation of HAP (hydroxyapatite) crystallites inside the prisms that became visible in the form of a series of fine points.
At a medium magnification, as seen in
Figure 7b, we noticed that in the eroded areas the prisms became very visible, having a circular depression aspect leading to a honeycomb type microstructure. This correlated with data from the literature showing that acid demineralization of prisms occurs with the dislocation of nanostructure HAP crystallites inside them, forming a honeycomb structure. The honeycomb-shaped portions were clearly distinguished from the unaffected enamel portions. Their morphology was more obvious at large magnification, as seen in
Figure 7c, where in the central part of the image we see the perfect enamel area, and towards the left and top left of the image appear the demineralized portions.
The overall appearance of the stained enamel with coffee solution is shown in
Figure 8a. We noticed that the coffee residues entered the depressions of the prisms caused by chewing and filling them. By this, we would expect a uniformity of the enamel surface but the detail at medium magnification, as seen in
Figure 8b, showed that there were crusts of thicker deposits that made the relief of the enamel significantly uneven. Alteration of the prisms was more obvious at high magnification, as seen in
Figure 8c. The upper corner of the image reveals partially altered prisms and the central part of the image shows completely destructed enamel. The microstructural detail, as seen in
Figure 8c, highlights such a deposition crust in which we observed advanced degradation of the enamel.
SEM analysis of the stained and bleached enamel with Opalescence gel revealed the smooth appearance of the enamel with small irregularities. We noticed a net change in appearance, highlighting the action of the bleaching gel by removing the chromophore deposits and traces of wear (
Figure 9) by comparison with the untreated group. The whitening produced by Opalescence gel removed both the deposition crusts and the deposits penetrating the depressions in the prisms. Thus, the overall appearance of the enamel, as seen in
Figure 9a, was much smoother and of a higher quality than the untreated healthy enamel. However, looking in more detail, as seen in
Figure 9b,c, we observed significant morphological alterations in the enamel surface consistent with the data in the literature [
15,
16].
SEM analysis of the stained and bleached group with experimental bleaching gel led to the images in
Figure 10. Both overall and in detail, there was an incredibly good removal of chromophore deposits and a restoration of enamel quality, very close to the perfect areas observed in untreated healthy enamel. The details in
Figure 10b,c show how the experimental gel led to a very good restoration of the demineralized areas, completely filling the depressions in the prisms. A nanostructural analysis performed with atomic force microscope (AFM) is needed to highlight the restructuring of the HAP crystallite architecture.
The HAP prisms of enamel had diameters between 5 and 7 µm, as shown from SEM imaging. The enamel surface was investigated by atomic force microscopy at a scanning area with a side of 5 µm in order to observe their fine microstructure.
The healthy, untreated enamel, as seen in
Figure 11a, captured in the central part of the image the appearance of the perfect enamel area, where the HAP crystallites were very well welded together. In the upper right corner of the image we noticed the edge of a depression sign that this portion corresponded to the edge of a partially demineralized prism, in line with those observed by SEM. Overall the surface was smooth and compact, resulting in a low roughness (
Table 2).
The effect of enamel staining with coffee solution was dramatic at the fine microstructural level, as seen in
Figure 11b, highlighting massive deposits that had a deep uneven effect that caused a significant increase in roughness and the disappearance of the enamel-specific structure. This shows that it was completely covered with coffee grounds.
After the bleaching process with Opalescence gel, the results showed a visually impressive enamel surface, confirmed by the quality of the AFM image in
Figure 11c. The appearance of the surface was smooth and quite compact. The crystals observed on the surface were much larger and duller than those typical for healthy enamel. Probably, the Opalescence gel is very efficient in removing stains and chromophore residues and also acts on HAP crystallites, causing a relative chemical erosion of them. Thus, the roughness decreased significantly, but did not reach the typical value for healthy enamel.
The treatment with the experimental gel led to an enamel surface very close to that of the healthy one, as seen in
Figure 11d. The appearance of the enamel after this treatment was compact with HAP crystallites very well welded together. The roughness decreased to a value close to that of healthy enamel after treatment (
Table 2). This highlights a much gentler and more efficient cleaning of the enamel by the action of experimental gel.
The evolution of the appearance and diameter of HAP crystallites was studied with the AFM microscope at a scanning area with a side of 1 µm. The healthy enamel, as seen in
Figure 12a, showed a compact structure of HAP nano-crystallites with a rounded shape and a diameter of 40 nm very well welded together. After staining with coffee, a degradation of the enamel nanostructure was observed, as seen in
Figure 12b, which was manifested by the appearance of deposits and by the relative alteration of the crystallite size, increasing from 40 to 65 nm. This is normal, if we take into consideration the deposits that have adhered to the surface, causing an effective doubling of the surface roughness.
After the treatment with Opalescence gel, we noticed that the enamel surface became very clean and free of impurities, but the morphology of HAP crystallites remained significantly altered, such that the nanoparticles had an eroded, blunt appearance, with diameters around 80 nm. Therefore, the major change induced by Opalescence occurred at the nanostructural level. Of course, this change had a very aesthetic overall appearance of bleached teeth, but the durability over time of the newly formed structure remains debatable, especially due to the remaining roughness, which was 14.7 nm. The edges of the nanocrystallites, as seen in
Figure 12c, could very easily become support for future deposits.
The experimental gel treatment also worked optimally at the nanostructural level, as seen in
Figure 12d. We noticed a compact and smooth surface, very similar to the healthy enamel after the treatment. The transformation of the situation in
Figure 12b into that of
Figure 12d took place with a gentle removal of impurities, as well as facilitating the local remineralization of the enamel. The diameter of the HAP crystallites after treatment with the experimental gel was very close to the diameter of HAP prisms of healthy enamel, and the value of roughness at the nano level was very close.
Summarizing the microstructural and nanostructural aspects, we can conclude that the Opalescence gel had a strong aesthetic effect that involved quite severe changes in the enamel, including morphological alterations, and the experimental gel gave the enamel a typical aesthetic appearance for a clean and well maintained natural tooth involving a gentle cleaning mechanism that protects the mineral structure of the enamel starting from the nanostructural level.
4. Discussion
The results of the study indicate more important antimicrobial activity in the case of inoculation of 50, as well as 100 µl extract solutions of 50% concentration. The most significant antimicrobial activity was present in the case of
Peptostreptococcus anaerobius. Some studies have shown the presence of
P. anaerobius in almost 90% of cases of periodontal disease in both women and men [
17]. The pathogens of periodontal disease have been detected not only in sick patients, but also in those who are apparently healthy [
17,
18,
19]. Research has also shown the presence of
P. anaerobius in root reinfections resulting from failed endodontic treatments [
20,
21,
22].
On the Streptococcus mutans strain, the extract solution showed significant antimicrobial activity, while the response of the C. xerosis strain was sensitive, depending on the amount and concentration of the experimental extract. On the C. albicans strain, the experimental formula based on Camellia sinensis had no antifungal effect.
Streptococcus mutans is a bacteria commonly found in the oral cavity. With the help of glycosyl transferase, the bacteria produce insoluble glucans, which adhere to the tooth surface, starting the formation of dental plaque. Under this film, the proliferation of
Streptococcus mutans occurs. During the proliferation process, sucrose produces lactic acid, which contributes to the demineralization of dental hard tissues [
23]. It has also been shown that the active substances contained in green tea extract, such as catechins, have the ability to inhibit the secretion of glucan, a substance secreted by
Streptococcus mutans [
24,
25]. This substance is involved in the formation of bacterial plaque [
26,
27]. Thus, both by inhibiting the growth of
Streptococcus mutans, the main cariogenic bacteria, and by inhibiting the proliferation of bacterial plaque, we can say that green tea extract has a carioprotective effect. In vivo and in vitro studies also support the anticariogenic effect of green tea extract by inhibiting the attachment of
Streptococcus mutans to hydroxyapatite crystals [
28].
Candida albicans is a saprophytic bacterial species, located in the oral and vaginal mucosa [
29], capable of causing infections in the case of decreased immune defense of the host organism, such as immunosuppressive infections, antibiotic medication, and immaturity of the immune system (newborns). Some studies have shown that low pH levels encourage the production and expansion of
Candida albicans colonies. It is also well known that a low pH in the oral cavity allows the development of dental plaque, especially in patients with high sugar diet [
30,
31]. It has been shown that in the presence of
Candida albicans, the production of glucans secreted by
Streptococcus mutans is increased and also the destructive capacity of
Streptococcus mutans is increased [
32]. In 1991, in the first study on the effect of green tea on
Candida albicans, the result was negative [
33]. It has been shown that low levels of EGCG, the main active component of green tea extract, have no antifungal action [
34]. Our results did not show any anti-fungal activity of the experimental extract. Previous studies have shown the antifungal effect of green tea only after it reached a pH of 6.5 [
35,
36]. Recent research in sensing technology concluded that pH sensors could be used in vivo or in vitro studies, due to their properties, such as biocompatibility, high precision, and fast and stable responses, in order to better understand the chemical processes during therapeutic and esthetic procedures in dentistry [
37,
38]. Other research has found that the most effective antifungal action is the combination of green tea extract and chloramphenicol [
36].
Numerous researches have shown that the effects of bleaching substances on tooth enamel are directly related to the concentration of carbamide peroxide; the higher the concentration, the more the surface roughness of the enamel suffers [
39]. This process is attributed to the oxidative action of the bleaching agent on the organic phase of the dental hard tissues [
40]. Other studies have shown that increasing the roughness of enamel after bleaching can promote the adhesion of
Streptococcus mutans to the tooth surface [
41].
Saliva has a cleansing function, but it also has a buffering action due to bicarbonate and phosphate systems. Some inorganic electrolytes contained in saliva (calcium, phosphorus, and fluoride) are important participants in the remineralization process. When the pH is below the physiological limit, some of the calcium and phosphorus complexes are released and added to the ionic-calcium and phosphorus reservoirs. Consequently, the apatite on the enamel surface is protected against dissolution [
42,
43].
Gonzalez-Lopez et al. reported that bleaching changed the organic composition in the enamel and decreased the phosphate and carbonate content, thus making the enamel surface rough and uneven [
43,
44].
In this context, researchers’ attention turned to the study of the actions of vegetable decoctions, which have been used since ancient times in both traditional Eastern and Western medicine for their anti-inflammatory and antibacterial effects [
36]. Recently, plants with healing properties have come to symbolize safety, as opposed to drugs made by chemical synthesis, which are now considered unsafe for both patients and the environment [
45]. Increasing the use of medicinal plants in medicine offers an important economic advantage in treating various diseases [
46]. Numerous natural extracts have been researched, such as propolis, orange oil, chamomile, and green tea. In this context, previous studies have concluded that green tea is a good chelating agent [
47] and inhibits the enzyme gyrase by binding to ATP (adenosine triphosphate) [
48]. Some research has shown a good antibacterial effect of green tea on endodontic microflora, including
E. faecalis [
49]. In periodontics, the literature has shown that green tea has the ability to inhibit lipopolysaccharide, which induces bone resorption [
50]. It has also been shown that the active substances in green tea extract, as well as in catechism, are a good adjunct during the professional hygiene procedure, by descaling and root planing of patients with chronic periodontitis [
51]. On cariogenic bacteria, some studies have shown the positive actions of green tea by inhibiting the growth of
S. mutans by decreasing bacterial adhesion on the tooth surface [
51].
Some studies have concluded that before the application of remineralizing agents, the application of tea-based preparations may be an acceptable option to remineralize demineralized dental hard tissues [
52,
53]. Other researchers concluded in a study that in addition to fluoride, the organic components of tea also have the property of increasing the acid resistance of tooth enamel. It also suggests that organic components appear to play a key role in their actions, rather than fluoride [
54]. Another study showed that toothpaste containing 15% green tea extract favored the remineralization of bleached enamel, showing an increased value of micro roughness [
55].
5. Conclusions
The green tea extract solution exerts an important antibacterial effect on P. anaerobius and S. mutans strains, the values of the inhibition diameters having values close to those of the reference antibiotics recommended by CLSI.
The natural extract based on Camellia sinensis has antimicrobial activity, conditioned by the dose against C. xerosis. The experimental extract has no antifungal action on the C. albicans strain. At the end of the bleaching treatment, both experimental groups showed a modified structure compared to the untreated control group.
Following Opalescence gel whitening, the surface of the enamel has a modified architecture compared to that of the healthy, untreated enamel, and the roughness has higher values than the control group.
The experimental group bleached with gel based on green tea extract and carbamide peroxide, although showing a prismatic appearance similar to that of the group bleached with Opalescence, had a roughness close to that of the control group, untreated due to the protective film of the green tea extract.